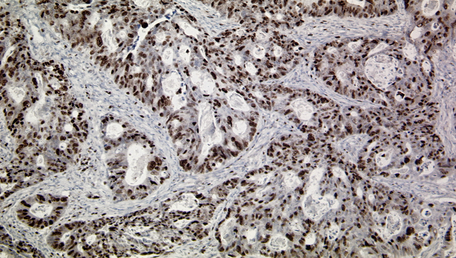

Liebe Patientinnen und Patienten, liebe Studierenden, liebe Besucherinnen und Besucher, liebe Kolleginnen und Kollegen,
ich begrüße Sie herzlich auf der Homepage des Instituts für Pathologie des Universitätsklinikums Düsseldorf. Auf diesen Seiten möchte ich Sie gerne über die Aufgaben und Leistungen der Pathologie informieren. Die Pathologie als Lehre von den Krankheiten ist ein zentrales Fach im Rahmen der Patientenversorgung, das als diagnostische Schnittstelle die verschiedenen konservativen und operativen Fächer der Medizin verbindet. Mit ihren klassischen morphologischen und zunehmend molekularen Ansätzen nimmt die moderne Pathologie eine entscheidende Rolle in der Krankenversorgung und in der Qualitätssicherung der Medizin ein. In der Rubrik „Diagnostik“ finden Sie umfassende Informationen über unsere Kompetenzbereiche, unsere Leistungen und Methoden. In der Rubrik „Informationen für Ärztinnen und Ärzte“ können Sie außerdem Anleitungen und Formulare für verschiedene Untersuchungen direkt ausdrucken.
Die Pathologie als Wissenschaft der Krankheitsursachen und -folgen ist ein grundlegendes Fach für alle klinischen Disziplinen und zahlreiche weitere wissenschaftliche Disziplinen. Unter der Rubrik „Lehre und Weiterbildung“ finden Sie Auskünfte über unsere curriculare Lehre für Studierende der Human- und Zahnmedizin und über weitere Lehr- und Weiterbildungsangebote des Institutes.
Die Forschung, sowohl als Grundlagenforschung als auch als translationale und klinisch angewandte Wissenschaft ist der dritte Hauptaufgabenbereich der Pathologie. Die molekulare Onkologie stellt den Schwerpunkt der wissenschaftlichen Aktivitäten des Institutes dar. Detaillierte Informationen über unsere Arbeitsgruppen und Projekte finden Sie in der Rubrik „Forschung“.
Falls Sie nähere Informationen über unsere Leistungen benötigen, z.B. für eine Zweitmeinung, zögern Sie nicht sich mit uns per E-Mail, telefonisch oder persönlich in Verbindung zu setzen. Für Verbesserungsvorschläge, Anregungen und Kritik sind wir jederzeit dankbar.
Herzlichst
Ihre
Irene Esposito
Institutsleitung/Direktorin

Unser Institut beteiligt sich am "SPATIAL"-Projekt der DSO
Die Düsseldorf School of Oncology (DSO) des Universitätstumorzentrums (Center for integrated Oncology Düsseldorf) initiiert das interdisziplinäre Forschungsprojekt "SPATIAL" - Systematic Phenotyping to Analyse Tumour-Immune interActions in Liquid and solid malignancies. Unser Institut beteiligt sich mit dem Teilprojekt "Spatial immunomodulation in gastroenteropancreatic neuroendocrine tumors and draining lymph nodes". Am Beispiel Gastroenteropankreatischer Neuroendokriner Tumoren (GEP-NETs) sollen Muster Tumor-abhängiger Immunmodulation im Primärtumor sowie im drainierenden Lymphknoten identifiziert und korreliert werden. Den Projekten unserer Partner stehen wir mit fachlicher Expertise und technischem Know-how zur Seite. Weitere Informationen unter: School of Oncology ǀ UKD (uniklinik-duesseldorf.de)